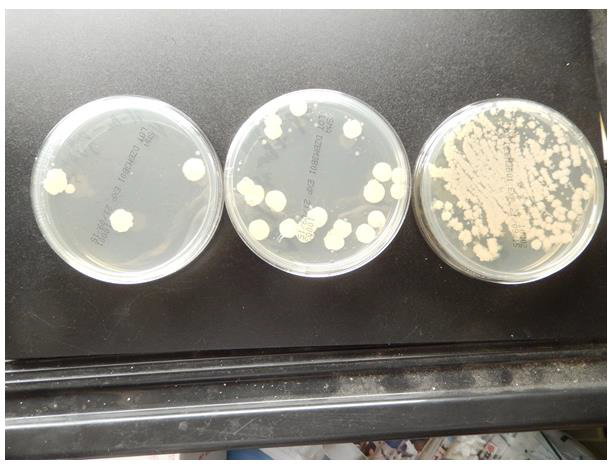

Research Article 
 Creative Commons, CC-BY
Creative Commons, CC-BY
Synthetic DNA (Human Placenta) Crown Cells Elongate Bacillus Subtilis-Elongation Occurs with the Combination of Sphingosine and DNA
*Corresponding author: Shoshi Inooka, Japan Association of Science Specialists, 3-8-2 Nakada, Taihaku-ku, Sendai 981-1104, Japan
Received: October 29, 2021; Published: November 05, 2021
DOI: 10.34297/AJBSR.2021.14.002026
Abstract
DNA crown cells are artificial cells in which the outer cell membranes are covered with DNA. These cells can be easily synthesized with a sphingosine (Sph)-DNA-adenosine mixture (synthetic DNA crown cells) and multiplied within egg whites (DNA crown cells). Currently, many kinds of both types of DNA crown cells have been prepared using DNA from various species. It was previously demonstrated that various types of assemblies are formed when synthetic DNA (E. coli) crown cells are mixed with Bacillus subtilis, and long objects similar to bacteria were observed within the assemblies.
Similar long objects within assemblies could be also observed in human placenta synthetic DNA crown cells; however, it remains un-tested whether long bacteria were bacteria. This study therefore clarified whether such long objects, which were observed in synthetic DNA (human placenta), could be cultivated under such conditions.
The results showed that long bacteria could be cultivated from assemblies that were formed using synthetic DNA (human placenta) crown cells and the B. subtilis was elongated by treatment with the combination of Sph and DNA . The findings suggest that the long objects were bacteria that were born in the association with synthetic DNA crown cells. On the other hand, whether the bacteria were transformed Bacillus needs to be ascertained in the future.
Keywords: Synthetic DNA Crown Cells; Assembly; Bacillus Subtilis; Sphingosine-DNA; Elongation
Introduction
There has been significant progress in the generation of artificial cells, and recently, approaches for generating fully functional (self-replicating) artificial cells have been reported [1,2]. Artificial cells that are covered with DNA, called DNA crown cells [3], can be synthesized using Sph-DNA-A-M mixtures (synthetic DNA crown cells) and are generated when they are incubated within egg whites (DNA crown cells), An unlimited number of both (synthetic DNA crown cells and DNA crown cells ) cells can theoretically be prepared, and several kinds of both DNA crown cells have been prepared [4-7].
In previous experiments on the functions of DNA crown cells, it was shown that assemblies of varying shapes and sizes can be formed when synthetic DNA (E.coli and human placenta) crown cells are mixed with Bacillus subtilis (natto) suspended in water [8,9]. In these experiments, bacteria, elongated objects like bacteria and DNA crown cells are observed within the assemblies. In this study, it was examined whether elongated objects like bacteria which were observed in combining synthetic DNA (human placenta) crown cells with B. subtilis [9] were bacteria.
Although crown cell synthesis systems have been described previously [9], briefly, synthetic DNA (human placenta) crown cells are prepared using Sph-DNA (human placenta), A-M compound-monolaurin and mixed with B. subtilis. Then, the mixtures are cultured to see whether elongated bacteria are present in the observed colonies. In addition, I attempted to clarify whether elongation of bacteria occurs in the association between synthetic DNA crown cells, the compounds of Sph-DNA binding (Sph-DNA), or the combination of Sph and DNA, i.e., the addition of Sph following DNA.
The elongation of bacteria was not observed when Sph-DNA were added to Bacillus subtilis ; rather, elongation was observed when Sph was added to bacteria, and then DNA was added to bacteria. It is interesting that synthetic DNA crown cells potentiate the ability to elongate bacteria, whereas Sph-DNA do not have this ability, or decrease this ability. Synthetic DNA crown cells are artificial cells in which Sph-DNA is modified by A-M compounds [10,11]. Therefore, it has been suggested that synthetic DNA crown cells acquired the ability to elongate bacteria by modification due to A-M compounds.
Materials and Methods
Materials
The following materials were used in the present study: Sph (Tokyo Kasei, Japan), DNA E. coli and human placenta (Sigma, USA), adenosine (Sigma, USA and Wako, Japan), monolaurin (Tokyo Kasei, Japan), and A-M compound (synthesized mixture of adenosine and monolaurin) [11]. Bacillus subtilis (natto) was prepared via culture (Daikokuya, Nagoya, Japan). Dry B. subtilis was cultured at 37°C for 18 h on agar, then bacteria were collected in distilled water at a concentration of approximately 106/ml. Normal agar medium (Sanisupetsuku, Azuwan, Japan) was used to culture B. subtilis.
Methods
Preparation of DNA (Human Placenta) Crown Cells and Of Sph-DNA : Synthetic DNA (human placenta) crown cells using Sph-DNA-AM were prepared as described previously [9]. Briefly, 180 μl of Sph (10 mM) and 90 μl of human placenta DNA (1.7 μg/μl) were mixed, and the mixture was cooled after heating. The procedures were carried out twice. Then, A-M compound (100 μl) was added to the mixture. The mixture was subsequently incubated at 37°C for 15 min before 30 μl of monolaurin was added and incubated at 37°C for 5 min. The results were used as a suspension of synthetic DNA (human placenta) crown cells.
Also, 180μl of Sph (10mM) and 90μl of DNA (E.coli, 1.7μg/μl) were mixed. The mixture was cooled after heating . The procedures were carried out twice. The mixtures were used as Sph-DNA.
Microscopic appearance of bacteria that survived in mixtures of synthetic DNA (human placenta) crown cells with subtilis:
Fifty microliters of a B. subtilis suspension were added to 50 μl of synthetic DNA (human placenta) crown cells and mixed. The mixtures were incubated for 3 and 24 h at 37°C. Then, 50 μl of the mixtures were plated on the agar and were incubated for 18 h at 37°C. Then, a sample from bacterial colony was spread on a slide glass and observed under a light microscope.Microscopic Appearance of Bacteria in Sph-DNA And the Combination of Sph And DNA Treated B. Subtilis:
A total of 50 μl of Sph-DNA were added to a 50 μl B. subtilis suspension and was incubated for 3 h at 37°C. Also, 25 μl of Sph (10 mM) was added to 50 μl of B. subtilis suspension and incubated for 5 min at 37°C. Then, 50 μl of DNA (1.7 μl/μl), which was heated and cooled, was added to the mixtures and incubated for 3 h at 37°C. Then, 50μl of each mixture was plated on an agar plate and incubated for 18 h at 37°C. Viable colonies were counted and a sample from the colonies was spread on a slide glass and covered with a cover slip and observed under a microscope.Results and Discussion
Elongated objects, like bacteria, were formed in the mixtures of synthetic DNA (human placenta) crown cells with B. subtilis
These results have been described previously [9]. Briefly, Figure1 shows the assemblies that were formed when synthetic DNA (human placenta) crown cells were mixed with B. subtilis. About 5 long bacteria-like objects were observed with or within the assembly (Figure 1 arrow a). Since it was unclear whether the long objects shown in (Figure1) were living (bacteria used in present experiments), I attempted to cultivate these long objects.
Growth suppression and microscopic appearance of surviving bacteria in the mixed cultures of synthetic DNA (human placenta) crown cells with B. subtilis
In a previous report on the assembly and combination of synthetic DNA (E. coli) crown cells with B. subtilis , it was demonstrated that growth of B. subtilis was suppressed, and that bacteria that survived were elongated compared to other bacteria observed under a microscope [12]. Here, it was examined whether such phenomena were observed when synthetic DNA (human placenta) crown cells were combined with B. subtilis.
After culturing mixtures of synthetic DNA (human placenta) crown cells with B. subtilis for 24 h at 37°C, 50 μl of the mixtures were plated and incubated for 18 h at 37°C . As shown in (Figure 2) right, about 100 colonies were observed, whereas numerous bacteria were observed in the sample without crown cells. The findings showed that synthetic DNA (human placenta) crown cells suppressed the growth of B. subtilis.

Figure 1: Long objects like bacteria within the assemblies that were formed when synthetic DNA (human placenta) crown cells are mixed with Bacillus subtilis. About five long objects like bacteria were observed with, or within, the assembly (Figure 1, arrow a). Also, an object like cell or bacteria was observed (Figure. 1, arrow b).

Figure 2: Growth suppression of bacteria in mixed cultures of synthetic DNA (human placenta) DNA crown cells and Bacillus subtilis. Synthetic DNA (human placenta) crown cells were cultivated with B. subtilis for 24 h at 37°C, the mixtures were plated and incubated for 18 h at 37°C. As shown in Figure 2 (right), about 100 colonies were observed, whereas numerous bacteria were observed in the sample without crown cells.
When three colonies were randomly selected and placed on a slide glass for microscopic observation, typical elongated/rod-like bacteria were observed (Figure 3 arrows, a and b). Free bacterium was also observed in Figure 3 (arrow c). The bacteria shown in Figure 3 (arrow b) were about 8 times as long as the bacteria shown in Figure 3 (arrow c). Thus, it was demonstrated that elongated bacteria can cultivate in the combination of synthetic DNA (human placenta) crown cells with B. subtilis,
Effect of Sph-DNA On Bacterial Growth and Elongation
Synthetic DNA crown cells were mainly constructed with Sph-DNA particles or fibers as described [10,11]. The role of Sph-DNA in the elongation B. subtilis was examined. Fifty micro liters of Sph-DNA was added to 50 μl of B. subtilis suspension and the mixtures were incubated for 3 h at 37°C. Then, 50 μl of the mixtures were plated on the agar medium and incubated for 18 h at 37°C. Then, the colonies were counted . Figure 4 shows the effect of Sph-DNA and the combination of Sph and DNA on the suppressing of bacterial growth and the picture in present experiment is shown in (Figure 4 (middle). About 18 colonies were observed, whereas numerous colonies were observed without Sph-DNA (Figure 4, right). The growth of B. subtilis was suppressed by the addition of Sph-DNA .

Figure 3: Microscopic appearance of a typical bacterium that survived after mixing synthetic DNA (Human placenta) with Bacillus subtilis. Three colonies were randomly selected, and samples were spread on glass slides for microscopic observation. A typical elongated bacterium is shown in Figure 3 (arrows a and b). A free bacterium was also observed in Figure 3 (arrow c).
Figure 4: (Middle) Effect of Sph-DNA on bacterial growth.
Sph-DNA solution was added to a Bacillus subtilis suspension and the mixture was incubated for 3 h at 37°C. Then, the mixtures were plated on
agar medium and incubated for 18 h at 37°C and the colonies were counted. Figure 4 summarizes the growth-suppression effect of Sph-DNA
binding and the combination of Sph and DNA on the bacterial growth-suppression. and the picture in present experiment is shown in Figure 4
(middle). About 18 colonies were observed, and numerous colonies were observed without Sph and DNA (Figure 4, right). Figure 4 (left) Growth
suppression in B.subtilis which were treated with the combination of Sph and DNA (Sph-treated, then DMA-treated).
Sph was added to a B. subtilis suspension and incubated for 5 min at 37°C. Then, treated DNA (E. coli) was added to the mixtures and incubated
for 3 h at 37°C. The mixtures were plated on agar and incubated for 18 h at 37°C and the colonies were counted. Three colonies were observed
(Figure 4, left).
Next, target bacteria from the colonies which selected at choice were placed on a glass slide and observed under a microscope. No elongated bacteria were observed (Figure 5, arrow). The findings showed that Sph-DNA has no effect on the elongation of B. subtilis, even if growth suppression was observed.

Figure 5: Microscopic appearance of bacteria that survived the addition of Sph-DNA Samples from the colonies (Figure 4 middle), which were randomly selected and spread on a glass slide and observed under a microscope. No elongated bacteria were observed (Figure 5, arrow).
Effect of the combination of Sph and DNA on the elongation of B. subtilis
Next, the effect of combination of Sph and DNA on elongation of B. subtilis was tested because Sph-DNA has no effect. First, 25 μl of Sph (10 mM) was added to 50 μl of B. subtilis suspension and incubated for 5 min at 37°C. Then, 50 μl of treated DNA (E. coli, 1.6 μg/μl) was added to the mixtures and incubated for 3 h at 37°C. Then, 50 μl of the mixtures were plated on the agar and incubated for 18 h at 37°C. Finally, the colonies were counted.
Three colonies were observed (Figure 4, left). The findings showed that the combination of Sph and DNA suppressed the growth of B. subtilis.
When target bacteria from the three colonies were spread on a glass slide and observed under a microscope, elongated bacteria were observed in samples from all colonies. The arrows a and b in (Figure 6) indicate typical elongated bacteria. Free bacterium was also observed in (Figure 6) (arrow c). The target bacteria are shown in (Figure. 7) Most of the bacteria appeared elongated (Figure 7, arrows a and b). Also, free bacterium is observed in Figure 7 (arrow c).

Figure 6: Microscopic appearance of a typical bacterium that survived mixing the cultures with the combination of Sph and DNA. Samples from three colonies were spread on a glass slide and observed under a microscope. A typical elongated bacterium is shown in Figure. 6 (arrows a and b).A free bacterium is shown in Figure 6 (arrow c).

Figure 7: General microscopic appearance of surviving bacteria shown in Figure 6. Most of the surviving bacteria had an elongated appearance (Figure 7, arrows a and b). A free bacterium is observed in Figure 7 (arrow c).
Elongated bacteria were not observed in the Sph-treated bacteria without DNA (unpublished data). These findings showed that elongated bacteria were formed due to the combination of Sph and DNA (i.e., Sph-treated, following DNA-treated). Thus, elongation occurs with the combination of Sph and DNA , and with synthetic DNA crown cells. At present, it is unclear whether elongation is based on the same mechanisms, but it may occur with Sph and DNA that were used to construct synthetic DNA crown cells. From these findings, long objects, which were observed within the assembly, were thus bacteria and were not formed in the bad environment of bacterial growth , but in the interrelation between systematic DNA crown cells and B. subtilis.
Regarding the mechanisms of elongation, these are considered to occur as follows:
First, Sph binds to B. subtilis and many B. subtilis died based on the toxic effect of Sph. Second, Sph binds to those B. subtilis that survived. Then, DNA binds to the Sph-bound B. subtilis. As a result, bacterial elongation occurs. Such elongation was observed in the use of synthetic DNA crown cells of E. coli and human placenta, but elongation was not observed in the use of synthetic DNA (Akoya pearl oyster and Streptomyces) (unpublished data), suggesting that the ability to elongate was not common in synthetic DNA crown cells, but characteristic in synthetic DNA crown cells. On the other hand, in this study, B. subtilis was used as the target organism. However, it is unclear whether bacteria other than B. subtilis can elongate.
In a previous report [13], it was demonstrated that synthetic DNA crown cells kill yeast. This time, it was shown that synthetic DNA crown cells elongate B. subtilis. Both findings indicate that synthetic DNA crown cells have at least two kinds of active physiological function. Also, in that study [12], it was shown that surviving bacteria were Brevi bacillus, which differed from the B. subtilis used in these experiments, suggesting that some form of genetic transformation occurred. However, it remains unclear whether elongation is under genetic control.
Finally, the reason why Sph-DNA has no, or little, effect on elongation, while synthetic DNA crown cells in which Sph-DNA was modified with A-M compounds has a marked effect on elongation may be the following. Synthetic DNA crown cells are living, albeit under special conditions, whereas Sph-DNA is non-living, compound. Hence, the present findings may help to resolve difficult subjects that have been discussed for a long time in the life sciences, such as the origin or the multiplicity of viruses, cells, and bacteria.
References
- Wagoner MD, Gonnah E, Towerki AA (2009) Outcome of Primary Adult Penetrating Keratoplasty in a Saudi Arabian Population. Cornea 28(8): 882-890.
- Wildsoet CF (1997) Active emmetropization--evidence for its existence and ramifications for clinical practice. Ophthalmic Physiol Opt 17(4): 279-290.
- Iribarren R, Morgan IG, Chan YH, Lin X, Saw S (2012) Changes in lens power in Singapore Chinese children during refractive development. Invest Ophthalmol Vis Sci 53(9): 5124-5130.
- Karunakar B, Rajlingam, Reddy L, Murthy S, Srikanth (2016) Axial length, corneal curvature and their association with the refractive status of the eye. Journal of Evolution of Medical and Dental Sciences 5(10): 422-426.
- Lin H, Wei C, Chang C, Chen T, Hsu Y, et al. (2016) Role of Chronic Inflammation in Myopia Progression: Clinical Evidence and Experimental Validation. E BioMedicine 10: 269-281.
- Rabin J, Van SRC, Malach R (1981) Emmetropization: a vision-dependent phenomenon. Invest Ophthalmol Vis Sci 20(4): 561-564.
- Mallen EAH, Gammoh Y, Bdour AM, Sayegh FN (2005) Refractive error and ocular biometry in Jordanian adults. Ophthalmic Physiol Opt 25(4): 302-309.
- Kotb M, Eissa SA (2021) Correlation Between Myopic Refractive Error, Corneal Power and Central Corneal Thickness in the Egyptian Population. Clin Ophthalmol 15: 1557-1566.
- Sanders DR, Koch DD (1993) An Atlas of corneal topography. Thorofare NJ, Slack.
- Almudhaiyan T, Alhamzah A, AlShareef M, Alrasheed A, Jaffar R, et al. (2020) The prevalence of refractive errors among Saudi adults in Riyadh, Saudi Arabia. Saudi J Ophthalmol 34(1): 30-34.
- Vergara C, Bomotti SM, Valencia C, Klein BEK, Lee KE, et al. (2018) Association analysis of exome variants and refraction, axial length, and corneal curvature in a European-American population. Hum Mutat 39(12): 1973-1979.
- Hashemi H, Khabazkhoob M, Miraftab M, Emamian MH, Shariati M, et al. (2013) Axial length to corneal radius of curvature ratio and refractive errors. J Ophthalmic Vis Res 8(3): 220-226.
- Ore L, Garozli HJ, Schwartz N, Cohen DM (2014) Factors influencing prevalence of vision and ocular abnormalities among Jewish and Arab Israeli schoolchildren. Isr Med Assoc J 16(9): 553-558.
- Hashmani N, Hashmani S, Hanfi AN, Ayub M, Saad CM, et al. (2017) Effect of age, sex, and refractive errors on central corneal thickness measured by Oculus Pentacam. Clin Ophthalmol 11: 1233-1238.
- Damji KF, Muni RH, Munger RM (2003) Influence of Corneal Variables on Accuracy of Intraocular Pressure Measurement. J Glaucoma 12(1): 69-80.
- Tang M, Li Y, Avila M, Huang D (2006) Measuring total corneal power before and after laser in situ keratomileusis with high-speed optical coherence tomography. J Cataract Refract Surg 32(11): 1843-1850.
- Mirna ŠŠ (2016) RISK FACTORS FOR CONTACT LENS COMPLICATIONS. Zdravniški vestnik 85(2).
- Sheng H, Bullimore MA (2007) Factors Affecting Corneal Endothelial Morphology. Cornea 26(5): 520-525.
- Zeried FM, Alnehmi DA, Osuagwu UL (2020) A survey on knowledge and attitude of Saudi female students toward refractive correction. Clin Exp Optom 103(2): 184-191.
- Thibos NL, Wheeler NW, Horner ND (1997) Power Vectors: An Application of Fourier Analysis to the Description and Statistical Analysis of Refractive Error. Optom Vis Sci 74(6): 367-375.
- Llorente L, Barbero S, Cano D, Dorronsoro C, Marcos S (2004) Myopic versus hyperopic eyes: axial length, corneal shape and optical aberrations. J Vis 4(4): 288-298.
- Ip JM, Huynh SC, Kifley A, Rose KA, Morgan IG, Varma R, et al. Variation of the Contribution from Axial Length and Other Oculometric Parameters to Refraction by Age and Ethnicity. Invest Ophthalmol Vis Sci 48(10): 4846-4853.
- Almahmoud T, Priest D, Munger R, Jackson WB (2011) Correlation between refractive error, corneal power, and thickness in a large population with a wide range of ametropia. Invest Ophthalmol Vis Sci 52(3): 1235-1242.
- Grosvenor T, Scott R (1991) Comparison of refractive components in youth-onset and early adult-onset myopia. Optom Vis Sci 68(3): 204-209.
- Müller A, Craig JP, Grupcheva CN, McGhee CNJ (2004) The effects of corneal parameters on the assessment of endothelial cell density in the elderly eye. Br J Ophthalmol 88(3): 325-330.
- Chang S, Tsai I, Hu F, Lin LL, Shih Y (2001) The cornea in young myopic adults. Br J Ophthalmol 85(8): 916-920.
- Cheung SW, Cho P (2000) Endothelial cells analysis with the TOPCON specular microscope SP-2000P and IMAGEnet system. Curr Eye Res 21(4): 788-798.
- Racz A, Toth GZ, Tarnoki AD, Tarnoki DL, Littvay L, et al. (2016) The inheritance of corneal endothelial cell density. Ophthalmic Genet 37(3): 281-284.
- MacRae SM, Matsuda M, Yee R (1985) The effect of long-term hard contact lens wear on the corneal endothelium. CLAO J 11(4): 322-326.
- Setälä K, Vasara K, Vesti E, Ruusuvaara P (1998) Effects of long-term contact lens wear on the corneal endothelium. Acta Ophthalmol Scand 76(3): 299-303.



 We use cookies to ensure you get the best experience on our website.
We use cookies to ensure you get the best experience on our website.